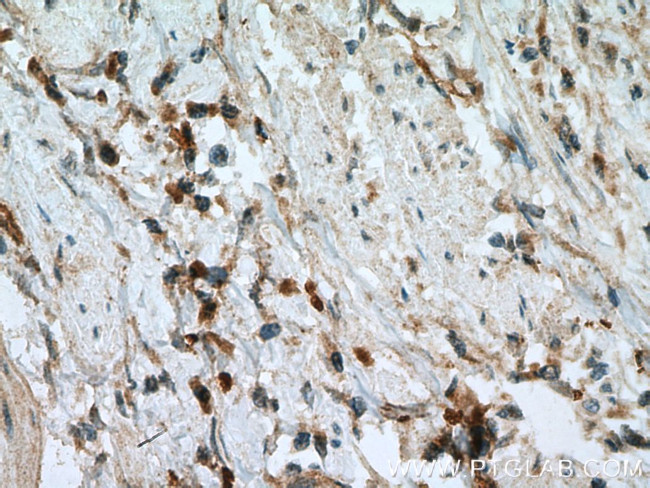
MIG Antibody in Immunohistochemistry (Paraffin) (IHC (P))

Search
Proteintech
MIG Polyclonal Antibody
{{$productOrderCtrl.translations['antibody.pdp.commerceCard.promotion.promotions']}}
{{$productOrderCtrl.translations['antibody.pdp.commerceCard.promotion.viewpromo']}}
{{$productOrderCtrl.translations['antibody.pdp.commerceCard.promotion.promocode']}}: {{promo.promoCode}} {{promo.promoTitle}} {{promo.promoDescription}}. {{$productOrderCtrl.translations['antibody.pdp.commerceCard.promotion.learnmore']}}
产品信息
22355-1-AP
种属反应
宿主/亚型
分类
类型
抗原
偶联物
形式
浓度
规格
纯化类型
保存液
内含物
保存条件
运输条件
产品详细信息
Immunogen sequence: TPVVRKGRC SCISTNQGTI HLQSLKDLKQ FAPSPSCEKI EIIATLKNGV QTCLNPDSAD VKELIKKWEK QVSQKKKQKN GKKHQKKKVL KVRKSQRSRQ KKTT (23-125 aa encoded by BC095396)
靶标信息
MIG, also known as CXCL9, is a T-cell chemoattractant inducible by gamma interferon that is a member of the CXC chemokine family of cytokines.This gene is mapped to 4q21. It is noted that, although the best-described activities of the chemokines are as chemotactic factors, chemokines also have an effect on T-cell activation, angiogenesis, and HIV infection. While most CXC chemokines are chemotactic for neutrophils, MIG and INP10 are unusual and similar in being CXC chemokines that are chemotactic for lymphocytes and inactive in neutrophils.
仅用于科研。不用于诊断过程。未经明确授权不得转售。
生物信息学
蛋白别名: C Cmotif chemokine; C X C motif chemokine; C-X-C motif chemokine 9; CC motif chemokine; CCmotif chemokine; chemokine (C-X-C motif) ligand 9; CXC; CXC motif chemokine; CXCL; Gamma-interferon-induced monokine; HuMIG; monokine induced by gamma interferon; Monokine induced by interferon-gamma; Small-inducible cytokine B9; unnamed protein product
基因别名: CMK; crg-10; CXCL9; Humig; MIG; SCYB9
UniProt ID: (Human) Q07325
Entrez Gene ID: (Human) 4283